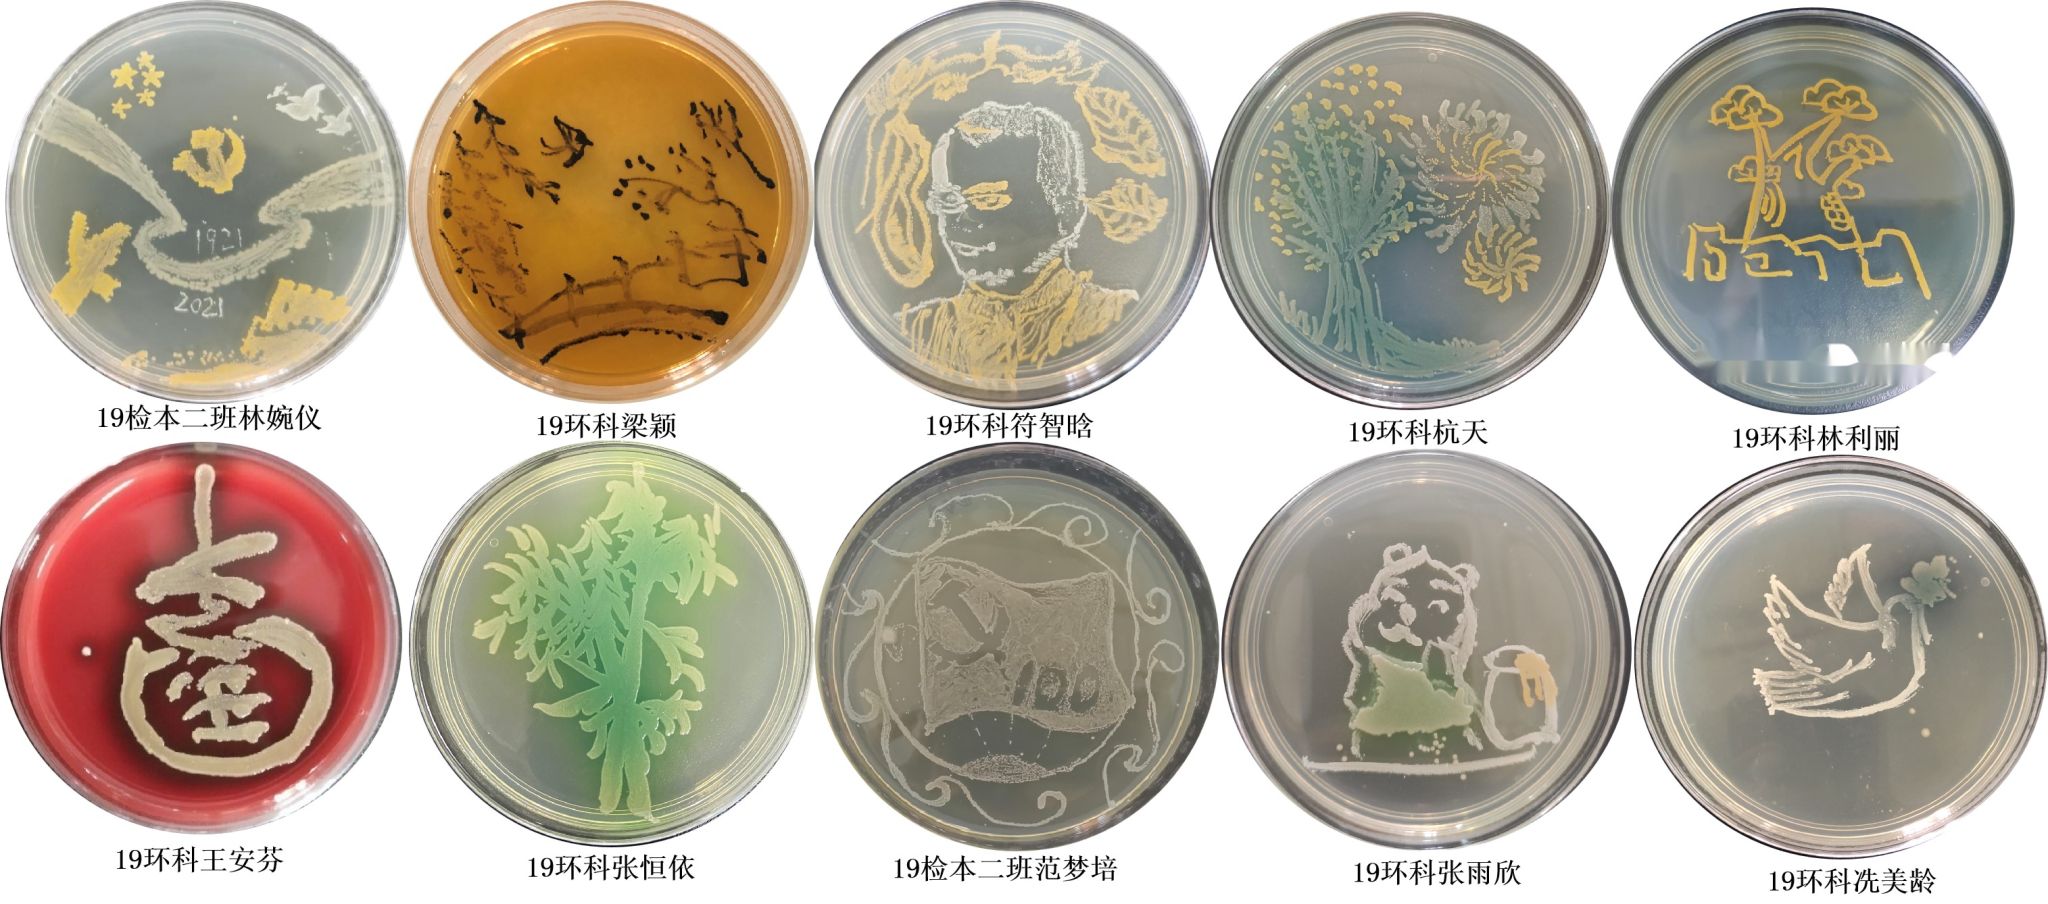

学院简介
一、学院历史
热带医学院,是集教学、科研和临床一体的培养医学检验技术、环境科学、卫生检验与检疫、临床医学(热带医学班)人才的摇篮。1973年招收检验中专生,1988年开始招收三年制医学检验专业大专生,2000年正式面向全国招收五年制医学检验专业本科生。2001年成立检验医学系,2009年12月成立热带医学与检验医学院,同年创办环境科学专业,2019年招收卫生检验与检疫专业本科生,2021年12月学院正式更名为热带医学院,2022年招收临床医学专业(热带医学班)本科生。目前学院以热带医学为特色,融合多学科,开展专科、本科、硕士、博士、博士后多层次高素质人才培养。
二、专业设置
1. 医学检验技术专业(四年制,授予理学学士学位)
国家级一流本科专业建设点、国家规划教材评审委员会委员单位、海南省特色专业建设点、全国医学检验教育分会副理事长单位、海南省应用型试点转型专业、taptap点点官网重点学科。
培养目标:培养适应我国医药卫生事业现代化发展需求,品德优良,具备扎实的医学检验技术和热带医学知识技能、良好的职业素养,能够在医疗卫生机构及相关科研机构从事临床医学检验、卫生检验及医学实验室工作,具有一定科研发展潜能的应用型高级医学检验专门人才。
就业方向:能够在各级医疗机构、医学检验中心、血站、疾病预防控制中心、环保和卫生检疫等部门从事医学检验工作。
2. 卫生检验与检疫专业(四年制,授予理学学士学位)
海南自由贸易港建设背景下的新办专业(2019年新办专业),卫生检验与检疫国家规划教材评审委员会委员单位。
培养目标:培养适应我国公共卫生事业、卫生检验检疫工作和社会现代化发展需要,德、智、体、美全面发展,具有一定的创新能力和科研发展潜能,具备卫生检验与检疫专业的基本知识和技能、一定的热带健康危险因素的检验检疫能力,能够胜任疾病预防控制中心、海关口岸及卫生检验与检疫等相关机构的卫生检验工作及其他医学技术实验室工作的复合型人才。
就业方向:能在各级疾病预防控制中心、卫生检验中心、食品卫生监测机构、检验检疫机构和质量监督所等部门从事卫生检验检疫工作。
三、师资队伍
现有教职员工92名(含兼职教师7名),其中正高级职称人员19名,副高级职称人员32名,国家优青1名;博士生导师10名,硕士生导师26名;担任中华医学会分会秘书长1人,省级学会理事长和主委2人;“百千万人才工程”国家级人选1人、国家有突出贡献的中青年专家1人、海南省有突出贡献优秀专家2人、国务院政府特殊津贴专家1人;海南省领军人才4人、拔尖人才8人;海南省“南海名家”人选4人、海南省“南海名家”青年项目人选9人;海南省“515”层次人才7人;海南省首批“双百”团队1个;国家首届全国教材建设先进集体1个、海南省优秀教学团队1个。
四、教学教研
近5年来,学院积极推进专业教学改革,提高专业课程教研水平和教学质量。学院获批海南省高等教育省级教学成果奖一等奖1项、二等奖2项,海南省高校教育教学改革研究项目15项(重点项目6项)、海南省一流本科课程5项,海南省高校精品在线开放课程2项;教育部首批新工科研究与实践项目顺利通过验收;临床检验学教研室成功获评国家首届全国教材建设先进集体;实验诊断学课程入围首届全国高校教师教学创新大赛海南省赛,温莹莹教学团队获得第二届全国高校教师教学创新大赛三等奖。
五、学科建设
学院强学科建设,固研究根基,不断优化研究布局。目前特种医学为海南省重点学科,临床检验诊断学为海南医学院重点扶持A类学科,环境科学为海南医学院重点扶持B类学科。依托国家卫生健康委员会热带病防治重点实验室和P2实验室开展科研工作,已形成稳定的热带医学、临床检验诊断技术和环境监测三个研究方向。近5年,学院共承担传染病国家重大科技专项任务级课题2项,教育部援外项目1项,海南省重大科技计划项目(社会发展方向)1项,国家自然科学基金区域联合基金项目1项,海南省重大科技专项子课题3项,国家自然科学基金项目20项,海南省省厅级项目60余项,科研经费超4400万元,在Cell等高水平SCI收录杂志发表论文230余篇,获海南省自然科学一等奖1项、获第十届海南省青年科技奖1项、海南省科技进步奖二等奖和三等奖各1项、四川省科学技术进步奖二等奖1项、中华医学科技奖三等奖1项。
六、学生培养
学院提倡自主学习,注重个性化发展,促进学生知识、能力、素质的多元统一。知识竞赛、专业技能竞赛、挑战杯比赛、互联网+等让学生在比赛中收获知识,提高技能;师生大联欢、师生同乐游园等活动架起了老师与学生的桥梁,建立起更深厚的师生感情;学院的“好声音”、篮球赛、“小粉笔”学生模拟授课大赛等丰富的文体活动更是为各位学子提供了展示风采的舞台。
学院注重学科建设,坚持开拓创新;积极推进专业教学改革,提高专业课程教研水平和教学质量;提倡自主学习,注重个性化发展,促进学生知识、能力、素质综合提高,毕业生分布全国各地,已形成良好的品牌效应。
历经20余年艰苦奋斗,开拓创新,热带医学院呈现办学层次齐全,学术梯队合理,教学科研协同发展的良好局面。学院将继续强化热带医学特色,服务海南自由贸易港的建设。
招生咨询电话:0898-66989173
网站链接:https://www.hainmc.edu.cn/jyyxy/zsjy.htm

2022年省级教学成果奖二等奖

全国教材建设先进集体
专业介绍
卫生检验与检疫专业
卫生检验与检疫专业(四年制,授予理学学士学位):2019年新办专业,卫生检验与检疫国家规划教材评审委员会委员单位。核心教师共有14名。其中正高1名,副高3名;具有博士学位人员11人,其中包括1名海南省“千人专项”人才,3名拔尖人才,博士生导师1人,硕士生导师4人。共主持科研项目27项,共获批经费370余万元,其中国家级科研项目8项,省级科研项目15项(重大科技计划项目2项),市级项目4项。共发表科研论文175篇,其中SCI论文142篇,中文期刊论文33篇。
培养目标:能够适应我国公共卫生事业发展、服务海南省自由贸易港建设的全域性或区域性公共卫生人才。学生具备基础知识扎实、技能娴熟,同时具备创新能力和一定科研发展潜能德才兼备且适应时代潮流的“复合型”人才。
主要课程:卫生化学(卫检)、分析化学(卫检)、人体解剖生理学(丙)、医学细胞生物学(乙)、流行病学(丙)、预防医学(乙)、医学统计学、卫生微生物学(甲)、卫生检验仪器分析、卫生检验毒理学、卫生检验与检疫导论、临床医学概论、卫生检验检疫学、生物化学与生物化学检验、媒介生物学及其控制、免疫学与免疫学检验、分子生物学检验技术、临床医学检验技术、微生物学与微生物检验、水质理化检验、空气理化检验、食品理化检验、生物材料检验、化妆品理化检验、实验室管理与生物安全和动植物检验与检疫总共26门专业课。
就业方向:各级疾病预防控制中心、产品质量监督检验所、食品检验检测中心、海关技术中心、第三方检测公司或生物公司研发等部门或企业,从事理化、微生物检验检疫或生物产品研发工作。
医学检验技术专业
医学检验技术专业隶属于医学技术类,学制为四年,授予理学学士学位。taptap点点自1973年开始招收检验专业中专生,1988年起招医学检验专业专科生,2000年起正式招收本科生,经过50多年的发展,目前taptap点点官网医学检验技术专业已发展成国家级一流本科专业建设点、全国医学检验教育分会副理事长单位、海南省特色专业、海南省应用型试点转型专业,是taptap点点官网的重点扶持学科。
医学检验技术专业现有教师30人,高级职称21人,其中专任教师22人,教辅6人,另有兼职教师35人(含医院兼职教师),专任教师中博士学位16人,青年教师硕士以上比例达100%。国家优青1人、海南省领军人才3人、海南省拔尖人才1人、海南省“515”层次人才2人、入选海南省“南海名家”3人、入选海南省“南海名家青年项目”1人、海南省优秀科技工作者2人、海南省青年科技奖1人、taptap点点官网C类人才2人。
一、培养目标
培养热爱医疗卫生事业和医学检验技术专业,德、智、体、美、劳全面发展,具有社会责任感、创新精神和实践能力,掌握基础医学、临床医学、检验医学的基本知识、基本理论和基本技能,掌握现代仪器设备及先进医学检验技术,具有医学检验实验室检测和科研创新能力及终身学习能力,具有良好的中、英文沟通能力和信息获取、管理、应用能力。毕业后能够胜任医疗卫生机构及与医学检验专业相关机构的临床医学检验、输血检验、卫生检验、第三方医学检验中心、疾控中心或高科技生物研发公司及医学实验室工作的医学检验创新应用型人才。
(一)思想道德与职业态度目标
1. 树立科学的人生观和世界观,热爱祖国,忠于人民,对医学检验技术专业的特点和性质有正确的认知,对其发展创新具有责任感,初步形成以维护和促进人类生命健康为己任的专业价值观。
2. 关爱生命,尊重患者,体现人道主义精神和全心全意为患者服务的专业精神。能够理解并遵守医疗行业的基本法律法规和职业道德。
3. 理解医疗卫生领域职业精神的内涵,在工作中养成同理心、尊重患者和提供优质服务等行为,形成真诚、正直、团队合作和领导
力等素养。
4. 意识到自己专业知识的局限性,尊重其他卫生从业人员,并注重相互合作和学习。树立自主学习、终身学习的观念,认识到持续自我完善的重要性,不断追求卓越。
5. 具备正确的劳动观念,具备一定的劳动技能和体育、军事知识,符合国家规定的身体素质要求,身心健康,能够履行建设祖国和保卫祖国的神圣义务。具备一定的热带医学特色知识。
(二)知识和能力目标
1. 认知国家卫生工作及临床实验室管理相关的方针、政策和法规。
2. 理解本专业相关的数学、物理学、化学、生命科学、行为科学和社会科学等基础知识与科学方法,并能用于指导未来的学习和工作实践。
3. 理解临床生物化学检验、临床检验基础、临床免疫学检验、临床微生物学检验、临床血液学检测、临床输血技术和临床分子生物学检验等的基本理论、基本方法和技术。
4. 理解常用医学检验仪器的基本结构和性能并能正确使用仪器检测各类样本,具有对各类样本检测进行质量控制的能力。分析各类样本的检测要求及影响检测结果的常见因素。分析各种常见病、重大疾病的实验室检验项目和检测方法及结果的临床应用。
5. 关注医学检验技术发展动态。初步具备文献阅读并具备一定的科学研究及论文写作能力,记忆基本的专业英语知识并具备初步应用的能力。能够获取、甄别、评价并应用医学等科学文献中的证据。初步具备数理统计及计算机应用能力。
6. 了解医院医疗质量保障和医疗安全管理体系,明确自己的业务能力与权限,重视患者安全,及时提供辅助检查中对患者不利的危险因素。
7. 认知我国医疗卫生系统的结构和功能,以及各组成部门的职能和相互关系,理解合理分配有限资源的原则,以满足个人、群体和国家对健康的需求。
8. 具有良好的交流沟通能力,能够与医生、护士及其他医疗卫生从业人员有效交流。具有与受检者及其家属进行有效交流沟通的能力。
9. 具有自主和终身学习的能力,能够适应不断变化的社会健康保健需求。
(三)培养特色
本专业的开设旨在立足海南,面向全国,辐射“一带一路”沿线国家和地区,培养服务海南人民健康、服务社会发展、服务国家战略需求,适应海南自由贸易港建设需要的热带特色鲜明的国际化高水平检验医学专业人才。
二、主要课程及课程设置
(一)主要课程
生物化学与分子生物学、病理学、临床免疫学基础、病理生理学、临床医学概论、临床分子生物学检验技术、临床微生物学及检验、临床检验基础、临床输血与检验技术、临床生物化学检验技术、临床血液学检验技术、临床免疫学检验技术、临床寄生虫学及检验、临床检验仪器与技术,共14门课程。
(二)课程设置
所有课程包含以下几个模块:
必修课 :47门,共2550学时(不含自主学习238学时),其中通识教育版块830学时,专业基础版块768学时,专业核心版块840学时,专业拓展版块112学时。
选修课:分为通识教育选修课、专业拓展选修课,其中通识教育选修版块需修满5学分、专业拓展选修版块需修满6学分。第二课堂修满4学分。
三、就业方向
医学检验技术的毕业生,就业范围广泛,就业前景较好,能在各级医疗机构、医学检验中心、血站、疾病预防控制中心、环保和卫生检疫等部门从事医学检验工作,可在医疗器械公司从事医疗器械销售工作,亦可在生物技术公司从事试剂销售或研发工作。

第五届医学检验技术专业技能大赛


师生教研活动
微生物培养皿艺术创作大赛优秀作品